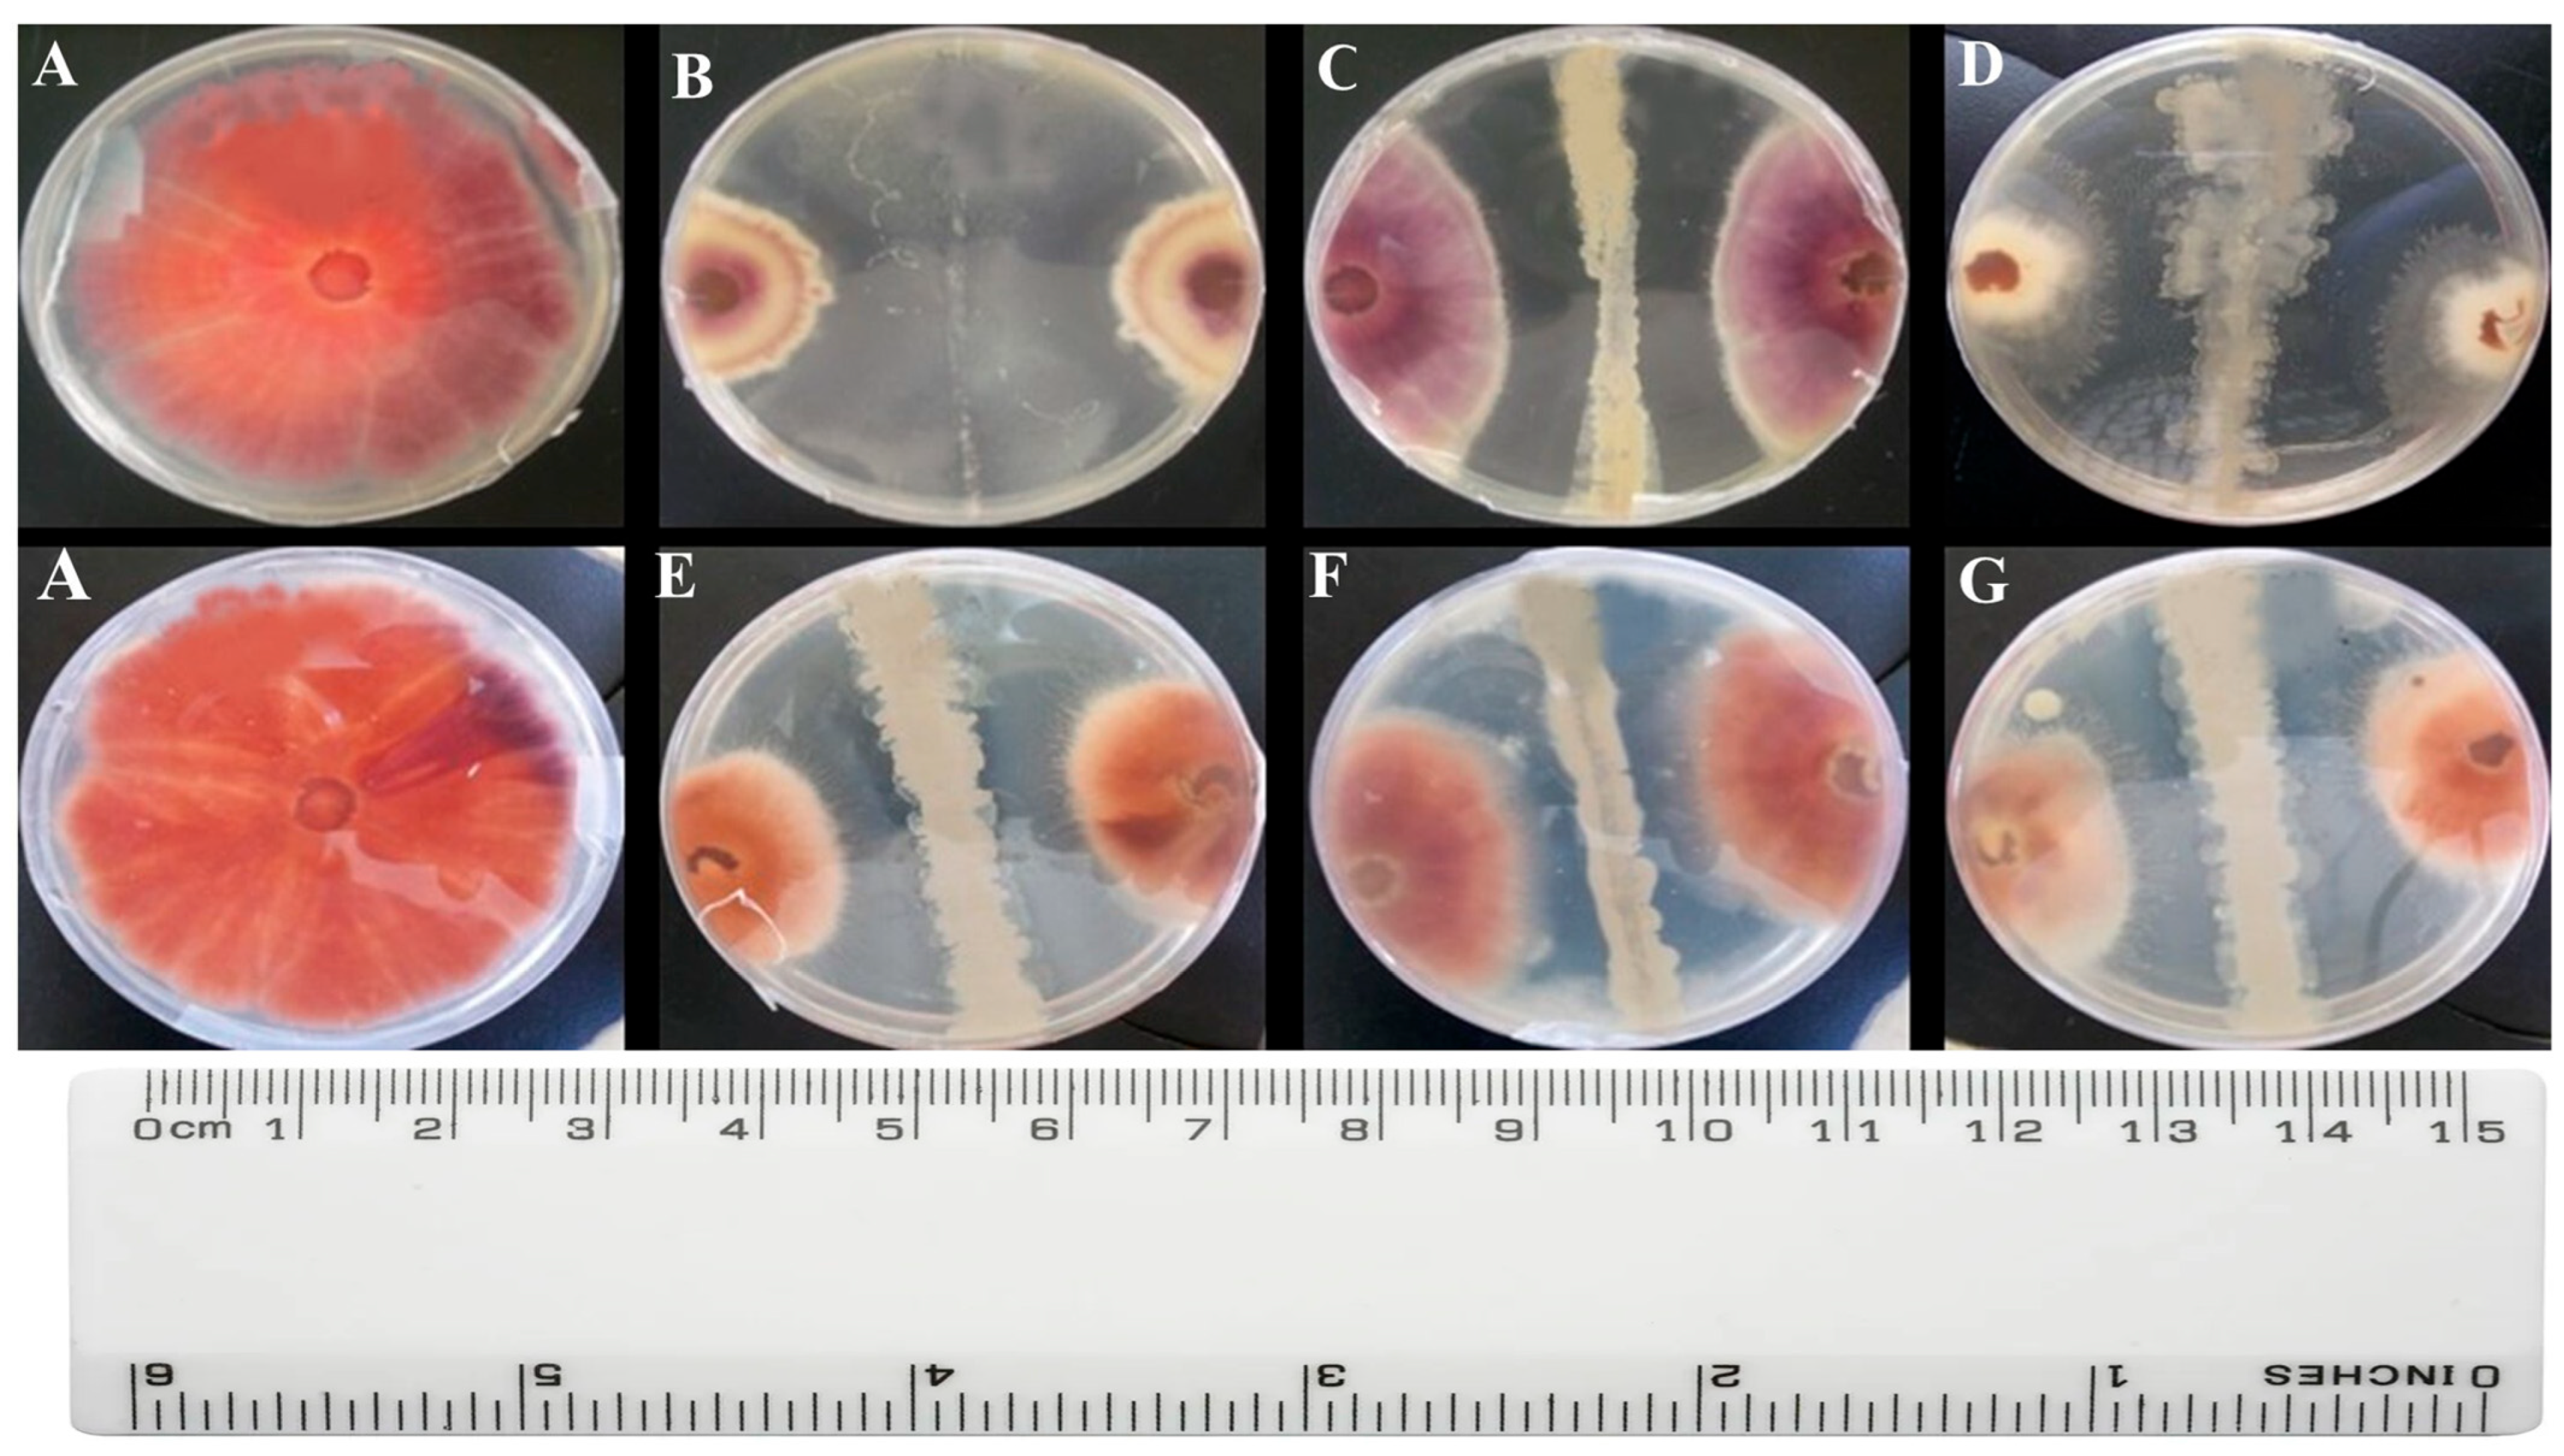
Bacteria 04 00039 g001

Abstract
Common bean (Phaseolus vulgaris L.) is a critical protein-rich legume supporting food and nutritional security globally. However, Fusarium wilt, caused by Fusarium solani, remains a major constraint to production, with yield losses reaching up to 84%. While biocontrol strategies have been explored, most microbial agents are sourced from mesophilic environments and show limited effectiveness under abiotic stress. Here, we report the isolation and characterization of extremophilic Bacillus spp. from the hypersaline Lake Bogoria, Kenya, and their biocontrol potential against F. solani. From 30 isolates obtained via serial dilution, 9 exhibited antagonistic activity in vitro, with mycelial inhibition ranging from 1.07–1.93 cm 16S rRNA sequencing revealed taxonomic diversity within the Bacillus genus, including unique extremotolerant strains. Molecular screening identified genes associated with the biosynthesis of antifungal metabolites such as 2,4-diacetylphloroglucinol, pyrrolnitrin, and hydrogen cyanide. Enzyme assays confirmed substantial production of chitinase (1.33–3160 U/mL) and chitosanase (10.62–28.33 mm), supporting a cell wall-targeted antagonism mechanism. In planta assays with the lead isolate (B7) significantly reduced disease incidence (8–35%) and wilt severity (1–5 affected plants), while enhancing root colonization under pathogen pressure. These findings demonstrate that extremophile-derived Bacillus spp. possess robust antifungal traits and highlight their potential as climate-resilient biocontrol agents for sustainable bean production in arid and semi-arid agroecosystems.
1. Introduction
In Kenya, Agriculture remains a foundational pillar of Kenya’s economy, contributing approximately 21.8% to the national GDP [1]. Within this sector, vegetable production plays a vital role in promoting food security and sustaining the livelihoods of smallholder farmers. Among the key vegetable crops, the common bean (Phaseolus vulgaris L.) is of particular dietary and economic importance. Known for its edible dry seeds and green pods [2], it is the second most consumed staple food in Kenya after maize, valued for its nutritional benefits, especially its high protein content and contribution to dietary diversity [3].
Beyond the seeds and pods, common bean leaves are occasionally utilized as leafy vegetables or livestock fodder [4]. Nutritionally, the crop is a rich source of protein, dietary fiber, thiamine, folate, and essential minerals such as iron and zinc nutrients commonly deficient in cereal- and root-based diets [1,2]. Additionally, common beans contain phytochemicals with analgesic and neuroprotective properties, further enhancing their health benefits [1]. Their high fiber content supports gastrointestinal health, stabilizes blood glucose levels, and promotes satiety, thereby aiding in weight management [5].
From an economic standpoint, common beans constitute a vital cash crop for Kenya’s smallholder farmers [6], contributing significantly to household incomes and rural economic development [7]. The beans are also exported to various international markets, where their distinctive flavor and quality have sustained high demand [7]. However, domestic production frequently falls short of meeting this demand, leading to substantial imports from neighboring countries, including Uganda, Ethiopia, and Tanzania [1].
This reliance on imports has coincided with heightened pest and disease incidence in bean production systems [8]. Major insect pests include cutworms, bean flies, aphids, pod borers, whiteflies, red spider mites, and thrips, while important diseases affecting the crop comprise black root rot, damping-off, bean rust, Fusarium wilt, bacterial blight, and downy mildew [9].
Soil infertility and increasing environmental stress have compounded these challenges, contributing to a 13.8% decline in bean yields over the past five years [10]. Particularly devastating is root and stem rot, which affects between 50% and 70% of bean crops and is predominantly caused by Fusarium solani [11]. This soil-dwelling fungus poses a significant challenge due to its capacity to persist as chlamydospores, colonize decaying organic matter, and spread via runoff and contaminated plant residues [12].
Symptoms of infection include irregular, light-brown lesions on the stem, taproot, and hypocotyl, which progressively darken and enlarge [13,14]. The pathogen typically enters through root wounds or natural openings, resulting in systemic infections that can cause yield losses of up to 70% [15,16]. These severe impacts underscore the pressing need for more effective and sustainable disease management strategies.
Control approaches for F. solani have included both chemical and cultural methods. While seed treatment with synthetic fungicides such as prochloraz, bromuconazole, and benomyl has shown efficacy against related Fusarium species [17], concerns persist regarding fungicide resistance and adverse effects on non-target organisms. As a result, there has been a growing emphasis on integrated cultural practices, including crop rotation, improved sanitation, and the use of genetically diverse cultivars, to reduce disease pressure and enhance soil resilience [18,19]. Other approaches include adjusting the sowing density and timing, selecting appropriate soil types [20], using resistant varieties or species mixtures [21], and practicing selective weeding [22].
Biological control offers a promising and sustainable alternative to conventional disease management approaches, including synthetic fungicides. It aligns well with environmentally conscious and pesticide-free agricultural systems. Among the most effective biocontrol candidates are strains from the Bacillus genus, which have demonstrated strong antagonistic activity against Fusarium species. Notably, Bacillus velezensis has shown potential in suppressing Fusarium solani [23], while Bacillus subtilis strain CAS 32 has been reported to effectively control F. solani-induced root rot in common beans [24]. Overall, members of the Bacillus genus are widely recognized for their capacity to mitigate Fusarium-related diseases in various crops [25]. Additionally, the study by Guevara-Avendaño et al. [26] reported that Bacillus spp. strains enhance the suppression of Fusarium wilt in radish. The antagonistic potential of Bacillus species against Fusarium solani has been widely explored to evaluate their effectiveness as biocontrol agents and to gain insight into the underlying mechanisms of suppression [27]. Both in vitro and in vivo experiments have been employed to assess the ability of Bacillus strains to inhibit F. solani and other pathogenic fungi, highlighting their broad-spectrum antifungal properties plant–pathogen interactions. These antagonistic effects are mediated through multiple mechanisms, including mycoparasitism, induction of systemic resistance in host plants, secretion of inhibitory secondary metabolites, stimulation of plant growth, competition for nutrients and ecological niches, and the production of cell wall–degrading lytic enzymes [27,28,29,30]. An emerging frontier in plant disease management involves exploring the microbial communities inhabiting Kenya’s extreme environments, particularly its soda lakes—Bogoria, Magadi, and Elementaita. These alkaline, saline ecosystems are known to host diverse extremophilic bacteria, as demonstrated by multiple studies investigating microbial populations in lake sediments, waters, and surrounding soils [31,32,33,34]. In a related investigation, Mutungi et al. [35] identified endophytic microbes associated with shrub vegetation along the receding shores of Lake Bogoria, targeting their potential to suppress Fusarium solani, a major pathogen of common beans in Kenya. These findings underscore the biocontrol potential of extremophilic bacteria from soda lakes in mitigating bean diseases. Among the promising candidates is Bacillus tequilensis, an extremophile isolated from the hypersaline environment of Lake Bogoria. This species exhibits both remarkable salt tolerance and broad-spectrum antifungal activity, making it a strong candidate for the development of sustainable, environmentally friendly plant protection strategies. Accordingly, the present study focused on isolating and evaluating Bacillus spp. from Lake Bogoria through both in vitro and in vivo assays to assess their efficacy as biocontrol agents against F. solani in common bean (Phaseolus vulgaris) production.
2. Materials and Methods
2.1. Description of the Sampling Site and Sample Collection
Lake Bogoria, located in Baringo County, Kenya, is a saline-alkaline lake recognized as a Ramsar site and designated as a national reserve since 2 November 1973. The lake is characterized by its high salinity, geothermal activity, and numerous hot springs and geysers along its shores, with temperatures exceeding 45 °C. It is relatively shallow, measuring approximately 34 km in length and 3.5 km in width. The lake’s waters are rich in sodium (Na+), bicarbonate (HCO3−; 34,950 mg/L), and carbonate (CO32−; 12,700 mg/L) ions, with a highly alkaline pH above 8.0 and temperatures ranging from 39.0 to 98.5 °C. For this study, purposive sampling was conducted at six distinct geothermal sites (hot springs) around the lake. From each location, soil samples (100 g) were collected in triplicate, and the corresponding physicochemical parameters were recorded (Table 1). The samples were placed in sterile tubes, stored in a cool box, and transported to the Jomo Kenyatta University of Agriculture and Technology (JKUAT) for subsequent laboratory analysis.
Table 1.
Sampling points with their physiochemical characteristics.
2.2. Isolation of Bacillus spp.
The isolation of Bacillus species from soil samples was carried out following the protocol described by Atlas [36], with slight modifications. Briefly, 1 g of each soil sample was suspended in 9 mL of sterile physiological saline solution (0.85% NaCl) and thoroughly homogenized. The resulting suspension was serially diluted (1:9) up to a 10−4 dilution. From each dilution, 30 µL aliquots were plated onto Nutrient Agar (HiMedia, Mumbai, India) and incubated at 30 °C for 48 h. Colonies exhibiting morphological characteristics typical of Bacillus spp. and showing bluish-green fluorescence under UV light (254 nm) were selected, sub-cultured for purification, and preserved for further characterization.
2.3. Antibiosis Assay of Bacillus spp. Isolates Against Fusarium solani
The antagonistic activity of Bacillus spp. isolates against Fusarium solani was evaluated using the dual culture technique, following the method described by Aydi et al. [37]. The assay was conducted on Sabouraud Dextrose Agar (SDA; HiMedia) composed of 10.0 g/L peptones, 40.0 g/L dextrose monohydrate, and 15.0 g/L agar, poured into 90 mm Petri dishes. Bacterial suspensions (108 CFU/mL) were streaked in a straight line across one side of the plate, while an 8 mm diameter mycelial plug of F. solani (ATCC 11712), actively cultured for five days, was placed on the opposite side. The fungal strain was previously isolated from infected common beans and obtained from Dudutech | Bioline Agrosciences Africa (Naivasha, Kenya). Control plates containing only the fungal plug at the center were also prepared. All assays were performed in triplicate, and plates were incubated at 30 °C for 14 days. The extent of fungal growth was determined by measuring the length of mycelial expansion in centimeters using a ruler with 1 mm precision.
2.4. Molecular Characterization of the Selected Bacterial Isolates
Genomic DNA was extracted from the two bacterial isolates exhibiting the strongest antagonistic activity against Fusarium solani using the Bacterial Genomic DNA Isolation Kit (Norgen Biotek Corp., Thorold, ON, Canada), following the manufacturer’s protocol. DNA quality and quantity were assessed using the Qubit 4 Fluorometer (Q33238), yielding an A260/280 ratio of 1.8. The DNA concentration was standardized to 100 ng/µL. Amplification of the 16S rRNA gene was carried out using the universal primers fD1 and rP1. PCR reactions were prepared in a total volume of 40 µL, comprising 20 µL of master mix, 18.2 µL of nuclease-free water, 0.4 µL each of fD1 and rP1 primers (10 pmol), and 1.0 µL of genomic DNA (10 ng/µL). Thermocycling was conducted using a Primus 96 thermocycler (PEQLAB, Erlangen, Germany) under conditions described previously by Wekesa et al. [23] The PCR amplicons were then purified using the QIAquick PCR amplification kit (Qiagen, Hilden, Germany) and sent to Macrogen (Seoul, Republic of Korea) for sequencing.
Phylogenetic Analysis
The Basic Local Alignment Search Tool (BLAST) from the National Center for Biotechnology Information (NCBI) site was used to compare the 16S rRNA of the bacterial isolates. The BLAST findings selected 16S rRNA gene sequences with the highest similarity index. The sequences were aligned using CLUSTAL W 2.0. and incorporated in MEGA 11 for pairwise and multiple sequence alignment [38]. Phylogenetic analysis was conducted using MEGA version 11, where the Kimura-2 parameter model was used to calculate the evolutionary distances and construct the phylogeny tree [38]. The evolutionary distance was calculated using the maximum composite likelihood technique. A bootstrap analysis of 1000 replicates denoted the evolutionary history of the already analyzed taxa.
2.5. Inoculum Preparation and Confrontation Assay
2.5.1. Inoculum Preparation
The bacterial strain B7 (1.0 × 1011 CFU/mL) and Fusarium solani (1.0 × 108 spores/mL) were employed to investigate bacterial–fungal interactions. Strain B7, which demonstrated the highest mycelial growth inhibition in dual culture assays, was initially cultured in Luria-Bertani (LB) broth (HiMedia; 10.0 g/L tryptone, 5.0 g/L yeast extract, 10.0 g/L NaCl) at 30 °C in a shaker incubator set at 120 rpm for 24 h. Subsequently, 0.5 mL of this culture was transferred to 50 mL of half-strength LB broth and incubated under the same conditions. The resulting bacterial suspension was used as inoculum for confrontation experiments.
The F. solani isolate, previously obtained from Dudutech Laboratory, had been confirmed through both morphological and molecular characterization. Its pathogenicity has been validated in earlier studies [39]. For this study, the isolate was sub-cultured on Sabouraud Dextrose Agar (SDA; HiMedia) at 28 °C for seven days. Spores were harvested following the method described by Chakravarthi et al. [40] and used as inoculum to assess the mycophagous activity of strain B7.
2.5.2. Confrontation Assay/Mycophagous Activity
The mycophagous interaction between strain B7 and Fusarium solani was evaluated to assess the bacterium’s ability to grow at the expense of the phytopathogen during direct contact. A confrontation assay was conducted using three treatments: T1—B7 inoculum alone, T2—F. solani inoculum alone (serving as the control), and T3—a combination of B7 and F. solani, following the method described by Báez-Astorga et al. [41]. All treatments were incubated at 30 °C in a shaking incubator at 120 rpm. At 12-, 24-, and 48-h post-inoculation, 200 µL aliquots were collected from each treatment to observe bacterial–fungal interactions under a light microscope, as previously described [41].
From each aliquot, 20 µL was placed onto a microscope slide, heat-fixed, and stained with 0.5% safranin for 30 s. Excess stain was removed by rinsing with distilled water, and the slides were air-dried. Microscopic examination was performed at 40× magnification, analyzing three random fields per replicate. The number of fungal hyphal segments was quantified for both the B7 + F. solani treatment and the F. solani-only control to determine the extent of bacterial colonization and interaction.
2.6. Screening for Genes Associated with Antibiosis
To determine the antibiotic genes responsible for antagonism, B7 bacteria were examined by PCR for the presence or absence of genes associated with antibiosis using specific gene primers (Table 2). Genes selected were coded for 2,4-diacetyl phloroglucinol (2,4-DAPG), pyrrolnitrin, phenazine-1-carboxylic acid, pyoluteorin, and hydrogen cyanide antibiotics. The primers were set in a PCR mixture with a total reaction volume of 25.0 µL consisting of 10.0 µL of master mix, 8.2 µL of PCR water, (10 ppm), 0.4 µL of the F primer, (10 ppm) of 0.4 µL of the R primer, and 1.0 µL of template DNA (10.0 ng/mL). The conditions of the PCR amplification cycle were initial denaturation at 95 °C for 5 min followed by 35 cycles of denaturation at 95 °C for 1 min, annealing at 68 °C/62 °C (Table 2) for 45 s, extension at 72 °C for 1 min, and final extension at 72 °C for 10 min. The presence or absence of the PCR amplicon was checked by electrophoresis (100 V for 45 min) in 1% agarose gels stained with ethidium bromide for band visualization using a Digi Doc imaging system (UVP, Cambridge, UK).
Table 2.
Target antibiosis genes that encode enzymes for the biosynthesis of various antibiotics in the B7 strain.
2.7. Production of Lytic Enzyme Activity
2.7.1. Chitinase Activity
The chitinolytic activity of strain B7 was assessed using a fluorometric chitinase assay kit (Sigma-Aldrich, St. Louis, MO, USA), following the manufacturer’s protocol. One unit of chitinase activity was defined as the amount of enzyme required to liberate 1 µmol of 4-methylumbelliferone per minute from the substrate. To further characterize enzymatic specificity, both endochitinase and exochitinase activities were evaluated using distinct substrates provided in the assay kit. Exochitinase activity was measured using N-acetyl-β-D-glucosaminide (GlcNAc) and N,N′-diacetyl-β-D-chitobioside (GlcNAc2), while endochitinase activity was assessed with β-D-N,N′,N″-triacetylchitotriose (GlcNAc3). All assays were performed in technical replicates to ensure accuracy and reproducibility.
2.7.2. Chitosanase Activity
The production of chitosanase by strain B7 was evaluated using chitosanase detection agar (CDA), following the method described by Fawzya and Chasanah [46]. Briefly, bacterial suspensions (1.0 × 108 CFU/mL) were applied onto sterile 6 mm white paper filter discs and allowed to air-dry. Discs inoculated with distilled water served as negative controls. Each disc was then placed on CDA plates (three discs per plate), and the plates were incubated at 28 °C for 48 h. Chitosanase activity was assessed by the formation of clear zones surrounding the bacterial discs, indicative of enzymatic degradation. The diameters of the clearance zones were measured using a ruler with 1 mm precision and recorded in centimeters.
2.8. In Vivo Antagonistic Potential of Selected B7. Using Pot Assays
An in vivo assay was conducted to assess the biocontrol efficacy of strain B7 against Fusarium solani-induced root rot and to monitor its concentration and persistence in the rhizosphere of common bean (Phaseolus vulgaris) under greenhouse conditions. The experiment employed a pot culture method as described by Wekesa et al. [47]. The bacterial inoculum was prepared by culturing strain B7 in 100 mL of nutrient broth (HiMedia) at 28 °C for 36 h in a shaker incubator at 120 rpm, and subsequently adjusted to a final concentration of 1.0 × 109 CFU/mL. The F. solani inoculum was generated by culturing the fungus in 250 mL of potato dextrose broth (PDB; HiMedia) at 28 °C for 14 days and standardized to 2.0 × 108 spores/mL. Common bean seeds (yellow variety) were surface sterilized by immersion in 70% ethanol for 30 s, followed by 5% sodium hypochlorite for 5 min, and rinsed three times with sterile distilled water. Seeds were sown (three seeds per pot) in pots (28 × 40 cm) containing 200 g of sterilized cocopeat substrate and maintained in a greenhouse for 35 days at temperatures ranging from 18–29 °C and relative humidity between 40–50%.
The experimental design followed a completely randomized block format with three replicates per treatment. The treatments were as follows: T1—F. solani inoculated five days prior to B7 application; T2—F. solani alone; T3—B7 alone; and T4—untreated control (no pathogen or bacteria). For treatments involving B7, the bacteria were applied at three intervals: 7, 14, and 28 days post-sowing, directly at the root zone. In the fungal infection protocol, bean seedlings were inoculated by immersing their roots for 2 h in F. solani spore suspension (2.0 × 108 spores/mL). Disease severity was scored weekly for three weeks using a 1–7 disease rating scale as described by Bock et al. [48], with plants categorized as wilted or unwilted. The number of symptomatic plants was recorded for each treatment.
2.9. Survival and Population Density of the B7 Strain in Common Bean Roots
The survival and population density of the inoculated bacterial strain were monitored following the method described by Sunyar [49]. Root samples were collected weekly from each treatment group and submerged in sterile distilled water (10 mL per 10 mg of root tissue). The samples were incubated in a rotary shaker for 2 h to dislodge rhizosphere-associated bacteria. From each suspension, a 200 µL aliquot was serially diluted up to 1010-fold (1:9 dilution ratio). Subsequently, 30 µL of the appropriate dilution was plated onto Nutrient Agar (HiMedia) and incubated at 25 °C for 48 h. Colony-forming units (CFUs) were enumerated under UV light to quantify bacterial populations.
2.10. Data Analysis
The raw data from antagonistic and confrontation assays and the production of lytic enzymes were subjected to a normality test using the Shapiro–Wilk test to evaluate the normal distribution. The data were also subjected to a homogeneity of variance test (Levene’s test) to check the assumption of equal variances across the data. The data were then subjected to Analysis of Variance (ANOVA) based on a linear model:
whereby the following:
Yij = μ + τi + εij
- Yij is the observed response;
- μ is the overall mean;
- τi is the effect of the i-th treatment (e.g., biocontrol strain or condition);
- εij is the random error associated with the j-th observation in the i-th treatment group, assumed to be normally distributed with mean zero and constant variance.
- to determine statistically significant differences at a threshold of p < 0.05. For means separation, the Least Significant Difference (LSD) test was used as a post hoc analysis using SAS version 8.0 software. Graphical presentation was performed using GraphPad Prism 6.
3. Results
3.1. Isolation and Antibiosis Assay
The isolated bacterial colonies from Lake Bogoria soil samples were used in preliminary dual culture tests with F. solani. A total of 30 bacterial isolates were isolated from the different sampling sites of L. Bogoria. Among the 30 bacteria tested, 9 bacterial strains showed a varied zone of inhibition (Table 3; Figure 1). Of the nine bacteria, two bacteria (B7-1.83 ± 0.09ab and B21-1.93 ± 0.07a) had the highest < 40% inhibition rate (Table 3; Figure 1).
Table 3.
Antagonistic activity of bacteria isolated against F. solani.
Figure 1.
Antibiosis assay of positive Lake Bogoria bacterial isolates against F. solani after 14 days of incubation at 30° C ± 2.0: (A) F. solani-only, (B) B30 and F. solani, (C) B29 and F. solani, (D) B21 and F. solani, (E) B38 and F. solani, (F) B11 and F. solani, and (G) B7 and F. solani.
3.2. Molecular Characterization of Selected Bacteria Isolates
Sequencing was performed on only two bacteria isolates with the highest > 40.0% inhibition rate from the dual culture technique. From the partial sequence, the BLASTn analysis showed that two isolates belong to the genus Bacillus (Table 4; Figure 2). The two isolates were also submitted to the NCBI GenBank and assigned accession numbers PP331233 and PP331234, respectively (Figure 2). The bacteria strain B7 was closely related to the Bacillus tequilensis strain IKAK46 with a percentage identity of 100% (Figure 2). However, the bacterial strain B21 was closely related to the strain of Bacillus subtilis subsp. Inaquosorum with a similarity index of 99.36% (Table 4).
Table 4.
Molecular identification of selected antagonistic bacterial strains using 16S rRNA genes with the corresponding GenBank accession numbers.
Figure 2.
Molecular phylogenetic analysis by maximum likelihood method. The evolutionary history was inferred by using the maximum likelihood method based on the Kimura-2 model. The tree is drawn to scale, with branch lengths measured in the number of substitutions per site. Evolutionary analyses were conducted in MEGA7.
3.3. Confrontation Assay/Mycophagous Activity
Microscopic examination revealed the inhibitory effects of strain B7 on F. solani mycelial growth at 24, 48, and 72 h in the B7 + F. solani treatment (Table 5). At 24 h, a reduced number of hyphal branches was observed in the B7 + F. solani treatment compared to the F. solani-only control (FSF). By 48 h, there was a slight increase in hyphal branching in the B7 + F. solani treatment relative to 24 h, but this remained lower than the control. In contrast, the F. solani control showed a consistent increase in hyphal development throughout the incubation period.
Table 5.
The number of branches of the mycelium of F. solani during the liquid confrontation assay between F. solani and Bacillus tequilensis strain IKAK46 B7.
3.4. Screening for Antibiosis-Associated Genes
The primers employed targeted genes associated with the biosynthesis of antibiotic metabolites active against phytopathogens. Among the six genes screened, three were successfully amplified by PCR (Table 6): phlD (involved in the production of 2,4-diacetylphloroglucinol), prnD (responsible for pyrrolnitrin synthesis), and hcnBC (linked to hydrogen cyanide production). The phzCD gene, which encodes enzymes for phenazine-1-carboxylic acid synthesis, was not detected. All amplified PCR products matched the expected size (Table 2).
Table 6.
In vitro screening for genes associated with antibiosis genes.
3.4.1. Chitinase Activity
Exochitinase activity, measured in terms of GlcNAc monomer production, was highest in the F. solani (F.S) treatment, ranging from 18.0 to 32.3 U/mL, compared to the B7 + F.S (7.0–9.3 U/mL) and B7 (1.3–3.7 U/mL) treatments (Table 7). In contrast, chitinase activity based on GlcNAc-2 was lowest in the F.S. treatment but significantly higher in B7 + F.S and B7 treatments, with the peak activity (3160.0 U/mL) observed at 72 h. A time-dependent increase in chitinase activity was evident in the B7 + F.S treatment. Endochitinase activity (GlcNAc-3) was predominantly detected in B7 and B7 + F.S treatments. While a decrease was noted in B7 alone over time, the B7 + F.S treatment exhibited a steady increase from 24 to 72 h, indicating a synergistic enhancement of enzyme production during bacterial–fungal interaction.
Table 7.
Chitinase activity between B7 and F. solani.
3.4.2. Chitosanase Activity
Chitosanase activity was significantly higher in the B7 + F. solani treatment compared to B7 alone, regardless of the incubation period. Across all treatments, chitosanase activity progressively increased from 24 to 72 h. The highest zone of inhibition was observed in the B7 + F. solani treatment at 72 h, measuring 29.0 ± 1.15 mm (Table 8). This indicates a synergistic induction of chitosanase production during the interaction between strain B7 and F. solani.
Table 8.
Chitosanase activity between F. solani and B7.
3.5. In Vivo Antagonistic Potential of Selected B7. Using Pot Assays
To evaluate the protective effect of Bacillus strain B7 against Fusarium solani, the percentage of disease incidence was assessed in both B7-treated and untreated common bean plants (Figure 3). Disease symptoms appeared in both groups by Day 7 post-inoculation. However, a marked difference in disease progression was observed. By Day 14, untreated plants exhibited a sharp increase in disease incidence, reaching 79.3%, whereas B7-treated plants showed significantly lower incidence at 35.6%. These results suggest that strain B7 provides substantial protection against F. solani infection, effectively reducing disease development over time (Figure 3).
Figure 3.
Percentage of disease incidence based on symptomatic plants per total number of plants observed infected with F. solani on the root of common beans, B7+: B7 treated; B7−: not treated. According to Fisher’s LSD test (p < 0.05), different superscript letters (a, b, c, d, e) indicate significantly different means within each parameter. The error bars indicate standard error (SE).
Figure 4 presents data on the number of wilted common bean plants over a 21-day period, highlighting the effect of Bacillus strain B7 inoculation on plants challenged with Fusarium solani. The untreated group (inoculated with F. solani only) exhibited a progressive increase in the number of wilted plants from Week 1 to Week 3, with the highest incidence recorded in Week 3 (18.0 wilted plants). In contrast, plants treated with strain B7 (B7 + F. solani) showed substantial protection, with markedly fewer wilted plants throughout the observation period. Within the treated group, no statistically significant differences were observed between Week 1 and Week 2, or between Week 2 and Week 3. However, a significant difference was observed between Week 1 and Week 3, with wilted plant counts slightly increasing from 2.0 (Week 1) to 5.0 (Week 3). These findings underscore the protective effect of strain B7 in mitigating disease severity caused by F. solani in common beans (Figure 4).
Figure 4.
Number of wilted plants observed for 3 weeks, B7+: B7 bacterial strain treated; F.S: Fusarium solani treated. According to Fisher’s HSD test (p < 0.05), different superscript letters (a, b, c, d, e) indicate significantly different means within each parameter. The error bars indicate standard error (SE).
3.6. Survival and Population Density of the B7 Strain in Common Bean Roots
The population density of Bacillus strain B7 on the roots of common bean plants was assessed using the colony-forming unit (CFU) counting method (Figure 5). Fluorescent observations of treatments T1 (B7 + F. solani) and T3 (B7 only) revealed viable bacterial populations on the root surfaces. The CFU counts, expressed as Log10 values, ranged from 5.8 to 7.0 for T1 and from 5.8 to 8.4 for T3. In contrast, no detectable CFUs were observed in treatments T2 (F. solani only) and T4 (untreated control), both of which recorded a count of 0 CFU. Notably, CFU levels in T1 and T3 increased during the first 14 days post-inoculation, followed by a gradual decline over time, indicating successful initial colonization of the root system by strain B7 and subsequent stabilization of its population dynamics (Figure 5).
Figure 5.
Population density of B7 strain on common bean root in greenhouse determined by the CFU counting method. Line T1: CFU of fluorescent B7 strain in treatment with B7 + F. solani treatment; T2: treatment with F. solani-only treatment; T3: CFU of B7 strain in treatment with B7-only treatment; T4: Absolute control (without pathogen or bacteria strain). The error bars indicate standard error.
4. Discussion
The potential of microorganisms from soda lakes as biocontrol agents against phytopathogens has been previously highlighted by Wekesa et al. [47]. Building on this concept, the current study investigated Bacillus spp. isolates from Lake Bogoria for their antagonistic activity against Fusarium solani, a major pathogen of common beans. Out of 30 bacterial isolates screened, 10 demonstrated varying degrees of mycelial growth inhibition. Notably, isolates B7 and B21 exhibited the highest antagonistic efficacy, each achieving inhibition rates exceeding 40%. These findings are consistent with those of Dugassa et al. [50], who reported that the cell-free culture filtrates of Bacillus spp. could suppress Fusarium mycelial growth by up to 71.11%. The observed inhibitory effects in our study may be attributed to the production of cell wall–degrading enzymes (CWDEs), as previously documented by Nehra et al. [28], who associated Bacillus-mediated antagonism with enzymatic lysis of fungal cell walls. Additionally, the inhibition may result from the secretion of diffusible antimicrobial compounds that interfere with fungal growth and proliferation [51].
The antagonistic interaction appeared to intensify between 48 and 72 h’ post-contact, suggesting inducible enzymatic responses during direct confrontation. Similar results were reported by Baard et al. [25], who described the enzymatic degradation of pathogenic fungal cell walls by biocontrol microbes in direct physical association. Thus, the mycelial inhibition observed in this study likely results from both antibiosis and enzyme-mediated suppression, reinforcing the biocontrol potential of Bacillus isolates from Lake Bogoria.
The results based on 16S rRNA; BLAST confirms the taxonomical identity of B21 as Bacillus subtilis subsp. Inaquosorum.
The isolate B7 demonstrated 97.5% sequence identity to known Bacillus species, suggesting it may represent a genetically distinct strain within the genus. Previous studies have documented the presence of Bacillus spp. and other Gammaproteobacteria in extreme environments, including soda lakes [52], with Gammaproteobacteria frequently identified as a dominant class. The sequence divergence observed in isolate B7 could reflect adaptive evolution to the harsh physicochemical conditions of Lake Bogoria, highlighting the potential of underexplored extreme environments as reservoirs for novel microbial strains with agronomic applications.
Following initial screening, isolate B7 was subjected to further molecular characterization to investigate the presence of genes associated with antibiosis. PCR amplification revealed the presence of several biosynthetic genes, including hcn, plt, prn, phz, and phl, which are involved in the production of hydrogen cyanide, pyoluteorin, pyrrolnitrin, phenazine, and 2,4-diacetylphloroglucinol (2,4-DAPG), respectively [53,54]. Notably, previous work by Kumar et al. [55] has reported the production of pyoluteorin by Bacillus spp., supporting our findings.
We also evaluated the production of lytic enzymes—specifically chitinase and chitosanase—which are key in fungal cell wall degradation [56]. Enzymatic assays revealed both exochitinase and endochitinase activity at 24-, 48-, and 72-h post-confrontation in the treatment with B7 and F. solani. Endochitinase cleaves internal bonds in the chitin polymer, creating substrates for exochitinase to further degrade the fungal cell wall. As chitin and its derivative chitosan are major structural components of the cell walls in filamentous fungi [57], degradation by bacterial chitosanase—alongside chitinase—plays a critical role in hyphal lysis [58]. The enzymatic action likely contributed to the observed reduction in hyphal branching and morphological abnormalities in F. solani, as visualized under light microscopy. Similar antagonistic effects have been reported by Báez-Astorga et al. [41] in Bacillus interactions with Rhizoctonia solani.
In the in vivo experiment, root colonization by strain B7 was confirmed using a culture-based approach. A higher recovery of fluorescent Bacillus colonies was recorded from roots treated with B7 compared to untreated controls, indicating successful root colonization even in the presence of F. solani. This observation is consistent with the findings of Bakki et al. [59], who emphasized the importance of microbial persistence for effective disease suppression. Colony counts from root samples confirmed that B7 maintained viable populations above the efficacy threshold required for biocontrol activity.
Moreover, disease incidence assessments revealed that plants treated with B7 exhibited significantly lower rates of wilting compared to those inoculated with F. solani alone. This protective effect is likely mediated through both direct antagonism and the induction of host defense responses, a well-recognized mode of action in plant-associated biocontrol bacteria [59].
In conclusion, Bacillus spp. isolated from Lake Bogoria exhibited potent antagonistic activity against F. solani, both in vitro and in vivo. Strain B7, in particular, demonstrated multiple biocontrol mechanisms, including production of antifungal secondary metabolites, lytic enzymes (chitinase and chitosanase), and robust root colonization. These attributes, combined with its adaptation to extreme environmental conditions, position B7 as a promising candidate for biocontrol applications, especially in arid and semi-arid lands (ASALs) where traditional biocontrol agents often fail to perform effectively.
Despite the promising results, this study is limited by the absence of field trials, which are essential to validate B7’s efficacy under natural agronomic conditions. Additionally, whole-genome sequencing of strain B7 was not conducted, which would be critical for confirming its novelty and biosynthetic potential. Nevertheless, the study’s strengths lie in its integrative approach—combining environmental microbiology, gene profiling, enzymatic assays, and in vivo evaluation—culminating in the identification of a highly promising biocontrol strain.
The findings support the broader potential of extremophilic microorganisms from soda lakes as sustainable alternatives to chemical fungicides. Strain B7, with its demonstrated antifungal activity, root colonization capacity, and environmental resilience, offers a valuable opportunity for advancing climate-smart agriculture. Future research should prioritize field validation and genomic analysis to fully harness the potential of such extremophile-derived biocontrol agents for use in Kenyan agriculture and beyond.
Author Contributions
Conceptualization, T.B.W.; methodology, T.B.W.; software, N.K.; validation, T.B.W.; formal analysis, T.B.W.; investigation, T.B.W.; resources, T.B.W. and J.M.O.; data curation, T.B.W.; writing—original draft preparation, T.B.W.; writing—review and editing, D.B., visualization, T.B.W. and N.K., supervision, T.B.W. and J.M.O.; project administration, J.M.O.; funding acquisition, J.M.O. All authors have read and agreed to the published version of the manuscript.
Funding
This project was funded by the Global Environment Facility (GEF-UNEP No: 82660) fund, and we are grateful for their financial support.
Data Availability Statement
Data used to support the findings of this study are available from the corresponding author upon request.
Conflicts of Interest
Author Tofick B. Wekesa was employed by Novo Science Bio Solutions Limited. The remaining authors declare that the research was conducted in the absence of any commercial or financial relationships that could be construed as a potential conflict of interest.
References
- Babirye, I.; Nakazi, F.; Birachi, E.A.; Wabbi, J.B.; Ugen, M.A.; Elepu, G. Exploring Processed Common Beans Market in Kenya: Implications for the Business Community. Cogent Food Agric. 2023, 9, 2175538. [Google Scholar] [CrossRef]
- Castro-Guerrero, N.A.; Isidra-Arellano, M.C.; Mendoza-Cozatl, D.G.; Valdés-López, O. Common Bean: A Legume Model on the Rise for Unraveling Responses and Adaptations to Iron, Zinc, and Phosphate Deficiencies. Front. Plant Sci. 2016, 7, 391–417. [Google Scholar] [CrossRef]
- Rathna Priya, T.S.; Manickavasagan, A. Common Bean. In Pulses: Processing and Product Development; Springer: Cham, Switzerland, 2020; pp. 77–97. ISBN 9783030413767. [Google Scholar]
- Blair, M.W.; Izquierdo, P.; Astudillo, C.; Grusak, M.A. A Legume Biofortification Quandary: Variability and Genetic Control of Seed Coat Micronutrient Accumulation in Common Beans. Front. Plant Sci. 2013, 4, 275. [Google Scholar] [CrossRef]
- Celmeli, T.; Sari, H.; Canci, H.; Sari, D.; Adak, A.; Eker, T.; Toker, C. The Nutritional Content of Common Bean (Phaseolus vulgaris L.) Landraces in Comparison to Modern Varieties. Agronomy 2018, 8, 166. [Google Scholar] [CrossRef]
- Uebersax, M.A.; Cichy, K.A.; Gomez, F.E.; Porch, T.G.; Heitholt, J.; Osorno, J.M.; Kamfwa, K.; Snapp, S.S.; Bales, S. Dry Beans (Phaseolus vulgaris L.) as a Vital Component of Sustainable Agriculture and Food Security—A Review. Legum. Sci. 2023, 5, e155. [Google Scholar] [CrossRef]
- Muteti, K.; Wambua, S.; Gichangi, A.; Mutua, M. The Household Income Determinants Crop Sales: The Case of Common Bean Production and Marketing in Selected Bean Corridors in Kenya. Afr. J. Rural Dev. 2022, 7, 399–411. [Google Scholar]
- Moorthy, P.N.K.; Kumar, N.R.P.; Mani, M.; Saroja, S. Pests and Their Management in Leguminous Vegetables. In Trends in Horticultural Entomology; Springer: Singapore, 2022; pp. 1031–1049. [Google Scholar] [CrossRef]
- Mani, M. Pest Management in Horticultural Crops Under Protected Cultivation. In Trends in Horticultural Entomology; Springer: Singapore, 2022; pp. 387–417. [Google Scholar] [CrossRef]
- Duku, C.; Groot, A.; Demissie, T.; Muhwanga, J.; Nzoka, O.; Recha, J. Common Beans Kenya: Climate Risk Assessment; SNV: Nairobi, Kenya, 2020. [Google Scholar]
- Zitnick-Anderson, K.; Oladzadabbasabadi, A.; Jain, S.; Modderman, C.; Osorno, J.M.; McClean, P.E.; Pasche, J.S. Sources of Resistance to Fusarium Solani and Associated Genomic Regions in Common Bean Diversity Panels. Front. Genet. 2020, 11, 475. [Google Scholar] [CrossRef]
- Gherbawy, Y.A.; Hussein, M.A.; Hassany, N.A.; Shebany, Y.M.; Hassan, S.; El-Dawy, E.G.A.E. Phylogeny and Pathogenicity of Fusarium Solani Species Complex (FSSC) Associated with Potato Tubers. J. Basic Microbiol. 2021, 61, 1133–1144. [Google Scholar] [CrossRef] [PubMed]
- Pierre, E.; Fabiola, Y.N.; Vanessa, N.D.; Tobias, E.B.; Marie-claire, T.; Diane, Y.Y.; Gilbert, G.T.; Louise, N.W.; Fabrice, F.B. The Co-Occurrence of Drought and Fusarium Solani f. Sp. Phaseoli Fs4 Infection Exacerbates the Fusarium Root Rot Symptoms in Common Bean (Phaseolus vulgaris L.). Physiol. Mol. Plant Pathol. 2023, 127, 102108. [Google Scholar] [CrossRef]
- Chenari, S.; Abbasi, S.; Chehri, K. Phylogeny and Host Specificity of Fusarium Solani Species Complex Isolated from Chickpea, Lentil and Common Bean. Arch. Phytopathol. Plant Prot. 2024, 57, 987–1001. [Google Scholar] [CrossRef]
- Araka, A.; Muraya, M.M.; Kuria, E.K. Prevalence of Bean Root Rot Pathogens in Tharaka Nithi County, Kenya. J. Sci. Technol. 2025, 30, 38–43. [Google Scholar] [CrossRef]
- Moparthi, S.; Burrows, M.; Mgbechi-Ezeri, J.; Agindotan, B. Fusarium spp. Associated with Root Rot of Pulse Crops and Their Cross-Pathogenicity to Cereal Crops in Montana. Plant Dis. 2021, 105, 548–557. [Google Scholar] [CrossRef]
- Ashraf, H.; Anjum, T.; Riaz, S.; Naseem, S. Microwave-Assisted Green Synthesis and Characterization of Silver Nanoparticles Using Melia Azedarach for the Management of Fusarium Wilt in Tomato. Front. Microbiol. 2020, 11, 238. [Google Scholar] [CrossRef] [PubMed]
- Larkin, R.P.; Brewer, M.T. Effects of Crop Rotation and Biocontrol Amendments on Rhizoctonia Disease of Potato and Soil Microbial Communities. Agriculture 2020, 10, 128. [Google Scholar] [CrossRef]
- Rani, A.T.; Vasudev, K.; Pandey, K.K.; Singh, B. Sucking Pests of Vegetable Crops. In Sucking Pests of Crops; Springer: Cham, Switzerland, 2020; pp. 307–340. [Google Scholar] [CrossRef]
- Quesada-Moraga, E.; González-Mas, N.; Yousef-Yousef, M.; Garrido-Jurado, I.; Fernández-Bravo, M. Key Role of Environmental Competence in Successful Use of Entomopathogenic Fungi in Microbial Pest Control. J. Pest Sci. 2023, 97, 1–15. [Google Scholar] [CrossRef]
- Kopp, E.B.; Niklaus, P.A.; Wuest, S.E. Ecological Principles to Guide the Development of Crop Variety Mixtures. J. Plant Ecol. 2023, 16, rtad017. [Google Scholar] [CrossRef]
- Monteiro, A.; Santos, S. Sustainable Approach to Weed Management: The Role of Precision Weed Management. Agronomy 2022, 12, 118. [Google Scholar] [CrossRef]
- Wekesa, T.B.; Wekesa, V.W.; Onguso, J.M.; Wafula, E.N.; Kavesu, N. Isolation and Characterization of Bacillus Velezensis from Lake Bogoria as a Potential Biocontrol of Fusarium Solani in Phaseolus vulgaris L. Bacteria 2022, 1, 279–293. [Google Scholar] [CrossRef]
- Abeysinghe, S. Biological Control of Fusarium solani f. sp. Phaseoli the Causal Agent of Root Rot of Bean Using Bacillus Subtilis CA32 and Trichoderma Harzianum RU01. Ruhuna J. Sci. 2007, 2, 82–88. [Google Scholar]
- Baard, V.; Bakare, O.O.; Daniel, A.I.; Nkomo, M.; Gokul, A.; Keyster, M.; Klein, A. Biocontrol Potential of Bacillus Subtilis and Bacillus Tequilensis against Four Fusarium Species. Pathogens 2023, 12, 254. [Google Scholar] [CrossRef]
- Guevara-Avendaño, E.; Bravo-Castillo, K.R.; Monribot-Villanueva, J.L.; Kiel-Martínez, A.L.; Ramírez-Vázquez, M.; Guerrero-Analco, J.A.; Reverchon, F. Diffusible and Volatile Organic Compounds Produced by Avocado Rhizobacteria Exhibit Antifungal Effects against Fusarium Kuroshium. Braz. J. Microbiol. 2020, 51, 861–873. [Google Scholar] [CrossRef]
- Sun, Z.; Hu, Y.; Yang, Y.-X.; Lei, M.-Y.; Han, Z.-M.; Cheng, L.; Wang, W.; Han, M.; Lyu, Z.-L.; Yang, L.-M.; et al. Changes in the Diversity of Ginseng Endophyte Flora Driven by Fusarium Solani. Front. Microbiol. 2025, 16, 1554706. [Google Scholar] [CrossRef]
- Nehra, S.; Gothwal, R.K.; Dhingra, S.; Varshney, A.K.; Solanki, P.S.; Meena, P.; Trivedi, P.C.; Ghosh, P. Mechanism of Antagonism: Hyperparasitism and Antibiosis. Microb. Biocontrol Sustain. Agric. Phytopathogen Manag. 2022, 1, 257–277. [Google Scholar] [CrossRef]
- Jaffar, N.S.; Jawan, R.; Chong, K.P. The Potential of Lactic Acid Bacteria in Mediating the Control of Plant Diseases and Plant Growth Stimulation in Crop Production—A Mini Review. Front. Plant Sci. 2023, 13, 1047945. [Google Scholar] [CrossRef]
- Khalil, M.S.M.; Hassan, M.H.A.R.; Mahmoud, A.F.; Morsy, K.M.M. Involvement of Secondary Metabolites and Extracellular Lytic Enzymes Produced by Plant Growth Promoting Rhizobacteria in Inhibiting the Soilborne Pathogens in Faba Bean Plants. J. Hama Dan Penyakit Tumbuh. Trop. 2022, 22, 100–108. [Google Scholar] [CrossRef]
- Schagerl, M. Soda Lakes of East Africa; Springer: Cham, Switzerland, 2016; ISBN 9783319286228. [Google Scholar]
- Kambura, A.K.; Mwirichia, R.K.; Kasili, R.W.; Karanja, E.N.; Makonde, H.M.; Boga, H.I. Bacteria and Archaea Diversity within the Hot Springs of Lake Magadi and Little Magadi in Kenya. BMC Microbiol. 2016, 16, 136. [Google Scholar] [CrossRef]
- Nyakeri, E.M.; Mwirichia, R.; Boga, H. Isolation and Characterization of Enzyme Producing Bacteria from Lake Magadi, an Extreme Soda Lake in Kenya. J. Microbiol. Exp. 2018, 6, 57–68. [Google Scholar] [CrossRef]
- Orwa, P.; Mugambi, G.; Wekesa, V.; Mwirichia, R. Isolation of Haloalkaliphilic Fungi from Lake Magadi in Kenya. Heliyon 2020, 6, e02823. [Google Scholar] [CrossRef] [PubMed]
- Mutungi, P.M.; Wekesa, V.W.; Onguso, J.; Kanga, E.; Baleba, S.B.S.; Boga, H.I. Culturable Bacterial Endophytes Associated With Shrubs Growing Along the Draw-Down Zone of Lake Bogoria, Kenya: Assessment of Antifungal Potential Against Fusarium Solani and Induction of Bean Root Rot Protection. Front. Plant Sci. 2022, 12, 796847. [Google Scholar] [CrossRef] [PubMed]
- Atlas, R.M. Handbook of Microbiological Media; CRC Press: Boca Raton, FL, USA, 2010. [Google Scholar]
- Aydi, R.; Abdallah, B.; Jabnoun-Khiareddine, H.; Nefzi, A.; Mokni-Tlili, S.; Daami-Remadi, M. Endophytic Bacteria from Datura Stramonium for Fusarium Wilt Suppression and Tomato Growth Promotion. J. Microb. Biochem. Technol. 2016, 8, 30–41. [Google Scholar] [CrossRef]
- Tamura, K.; Stecher, G.; Kumar, S. MEGA11: Molecular Evolutionary Genetics Analysis Version 11. Mol. Biol. Evol. 2021, 38, 3022–3027. [Google Scholar] [CrossRef] [PubMed]
- Falert, S.; Akarapisan, A. Identification of Fusarium spp. Causing Dry Rot of Seed Potato Tubers in Northern, Thailand. Int. J. Agric. Technol. 2019, 15, 567–578. [Google Scholar]
- Chakravarthi, B.V.S.K.; Singh, S.; Kamalraj, S.; Gupta, V.K.; Jayabaskaran, C. Evaluation of Spore Inoculum and Confirmation of Pathway Genetic Blueprint of T13αH and DBAT from a Taxol-Producing Endophytic Fungus. Sci. Rep. 2020, 10, 21139. [Google Scholar] [CrossRef] [PubMed]
- Báez-Astorga, P.A.; Cázares-Álvarez, J.E.; Cruz-Mendívil, A.; Quiroz-Figueroa, F.R.; Sánchez-Valle, V.I.; Maldonado-Mendoza, I.E. Molecular and Biochemical Characterisation of Antagonistic Mechanisms of the Biocontrol Agent Bacillus Cereus B25 Inhibiting the Growth of the Phytopathogen Fusarium Verticillioides P03 during Their Direct Interaction in Vitro. Biocontrol Sci. Technol. 2022, 32, 1074–1094. [Google Scholar] [CrossRef]
- Raaijmakers, J.M.; Weller, D.M.; Thomashow, L.S. Frequency of Antibiotic-Producing Pseudomonas spp. in Natural Environments. Appl. Environ. Microbiol. 1997, 63, 881–887. [Google Scholar] [CrossRef]
- de Souza, J.T.; Raaijmakers, J.M. Polymorphisms within the PrnD and PltC Genes from Pyrrolnitrin and Pyoluteorin-Producing Pseudomonas and Burkholderia spp. FEMS Microbiol. Ecol. 2003, 43, 21–34. [Google Scholar] [CrossRef]
- Mavrodi, O.V.; McSpadden Gardener, B.B.; Mavrodi, D.V.; Bonsall, R.F.; Weller, D.M.; Thomashow, L.S. Genetic Diversity of PhlD from 2,4-Diacetylphloroglucinol-Producing Fluorescent pseudomonas spp. Phytopathology 2001, 91, 35–42. [Google Scholar] [CrossRef]
- Ramette, A.; Frapolli, M.; Défago, G.; Moënne-Loccoz, Y. Phylogeny of HCN Synthase-Encoding HcnBC Genes in Biocontrol Fluorescent Pseudomonads and Its Relationship with Host Plant Species and HCN Synthesis Ability. Mol. Plant-Microbe Interact. 2007, 16, 525–535. [Google Scholar] [CrossRef]
- Fawzya, Y.N.; Chasanah, E. Isolation of Chitinolytic Enzymes and Development of Chitooligosaccharides in Indonesia. In Chitooligosaccharides; Kim, S.-K., Ed.; Springer: Cham, Switzerland, 2022; pp. 277–300. [Google Scholar] [CrossRef]
- Wekesa, T.B.; Wafula, E.N.; Kavesu, N.; Sangura, R.M. Taxonomical, Functional, and Cytopathological Characterization of Bacillus spp. from Lake Magadi, Kenya, against Rhizoctonia Solani Kühn in Phaseolus vulgaris L. J. Basic Microbiol. 2023, 63, 1293–1304. [Google Scholar] [CrossRef]
- Bock, C.H.; Chiang, K.S.; Del Ponte, E.M. Plant Disease Severity Estimated Visually: A Century of Research, Best Practices, and Opportunities for Improving Methods and Practices to Maximize Accuracy. Trop. Plant Pathol. 2022, 47, 25–42. [Google Scholar] [CrossRef]
- Sunyar, B.; Yeşildağ, M.F.; Alma, M.H. Effectiveness of Bacillus and Pseudomonas Strains in Biological Control of Common Bacterial Blight Disease in Common Bean (Phaseolus vulgaris L.). J. Crop Health 2024, 76, 1357–1372. [Google Scholar] [CrossRef]
- Dugassa, A.; Alemu, T.; Woldehawariat, Y. In-Vitro Compatibility Assay of Indigenous Trichoderma and Pseudomonas Species and Their Antagonistic Activities against Black Root Rot Disease (Fusarium solani) of Faba Bean (Vicia faba L.). BMC Microbiol. 2021, 21, 115. [Google Scholar] [CrossRef]
- Toghueo, R.M.K.; Eke, P.; Zabalgogeazcoa, Í.; de Aldana, B.R.V.; Nana, L.W.; Boyom, F.F. Biocontrol and Growth Enhancement Potential of Two Endophytic trichoderma spp. from Terminalia Catappa against the Causative Agent of Common Bean Root Rot (Fusarium solani). Biol. Control 2016, 96, 8–20. [Google Scholar] [CrossRef]
- Pellegrinetti, T.A.; Cotta, S.R.; Feitosa, Y.B.; Melo, P.L.A.; Bieluczyk, W.; Silva, A.M.M.; Mendes, L.W.; Sarmento, H.; Camargo, P.B.; Tsai, S.M.; et al. The Role of Microbial Communities in Biogeochemical Cycles and Greenhouse Gas Emissions within Tropical Soda Lakes. Sci. Total Environ. 2024, 947, 174646. [Google Scholar] [CrossRef] [PubMed]
- Mikiciński, A.; Puławska, J.; Molzhigitova, A.; Sobiczewski, P. Evaluation of Antagonistic Mechanisms of Bacterial Species Recognized for the First Time for Their Biocontrol Activity against Fire Blight (Erwinia amylovora). Eur. J. Plant Pathol. 2022, 156, 157–272. [Google Scholar] [CrossRef]
- Jain, R.; Pandey, A. A Phenazine-1-Carboxylic Acid Producing Polyextremophilic Pseudomonas Chlororaphis (MCC2693) Strain, Isolated from Mountain Ecosystem, Possesses Biocontrol and Plant Growth Promotion Abilities. Microbiol. Res. 2016, 190, 63–71. [Google Scholar] [CrossRef]
- Kumar, S.; Anjali; Arutselvan, R.; Masurkar, P.; Singh, U.B.; Tripathi, R.; Bhupenchandra, I.; Minkina, T.; Keswani, C. Bacillus Subtilis-Mediated Induction of Disease Resistance and Promotion of Plant Growth of Vegetable Crops. Microorg. Sustain. 2024, 51, 165–211. [Google Scholar] [CrossRef]
- Zhao, P.; Li, P.; Wu, S.; Zhou, M.; Zhi, R.; Gao, H. Volatile Organic Compounds (VOCs) from Bacillus Subtilis CF-3 Reduce Anthracnose and Elicit Active Defense Responses in Harvested Litchi Fruits. AMB Express 2019, 9, 119. [Google Scholar] [CrossRef] [PubMed]
- Barroso-Solares, S.; Lopez-Moya, F.; Fraile, T.; Prieto, Á.C.; Lopez-Llorca, L.; Pinto, J. Chitin and Chitosan Quantification in Fungal Cell Wall via Raman Spectroscopy. Spectrochim. Acta Part A Mol. Biomol. Spectrosc. 2025, 334, 125928. [Google Scholar] [CrossRef] [PubMed]
- Tamrela, H.; Sugiyanto, A.; Santoso, I.; Fadhilah, Q.G. The Qualitative Screening of Cellulolytic, Chitinolytic, IAA-Producing, and Phosphate Solubilizing Bacteria from Black Soldier Fly Larvae (Hermetia illucens L.). IOP Conf. Ser. Earth Environ. Sci. 2021, 948, 012065. [Google Scholar] [CrossRef]
- Bakki, M.; Banane, B.; Marhane, O.; Esmaeel, Q.; Hatimi, A.; Barka, E.A.; Azim, K.; Bouizgarne, B. Phosphate Solubilizing Pseudomonas and Bacillus Combined with Rock Phosphates Promoting Tomato Growth and Reducing Bacterial Canker Disease. Front. Microbiol. 2024, 15, 1289466. [Google Scholar] [CrossRef] [PubMed]
Disclaimer/Publisher’s Note: The statements, opinions and data contained in all publications are solely those of the individual author(s) and contributor(s) and not of MDPI and/or the editor(s). MDPI and/or the editor(s) disclaim responsibility for any injury to people or property resulting from any ideas, methods, instructions or products referred to in the content. |
© 2025 by the authors. Licensee MDPI, Basel, Switzerland. This article is an open access article distributed under the terms and conditions of the Creative Commons Attribution (CC BY) license (https://creativecommons.org/licenses/by/4.0/).